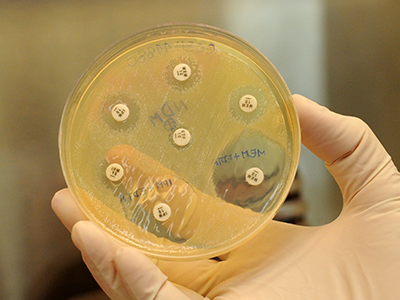

Especialista alertou que o uso indiscriminado de antibiĂ³ticos Ă© um dos problemas mais importantes a ser enfrentado
Este ano, o Dia de Combate Ă InfecĂ§Ă£o Hospitalar, celebrado em 15 de maio, foi precedido pela publicaĂ§Ă£o de um relatĂ³rio da OrganizaĂ§Ă£o Mundial da SaĂºde (OMS) que aponta que as bactĂ©rias resistentes a antibiĂ³ticos sĂ£o uma ameaça Ă saĂºde pĂºblica em todo o mundo. O documento mostrou que, em todas as regiões do planeta, jĂ¡ existem micro-organismos insensĂveis atĂ© mesmo Ă s drogas utilizadas como ‘Ăºltimo recurso’. Segundo a OMS, sem medidas urgentes, hĂ¡ o risco de que doenças hoje consideradas menores voltem a ser fatais. Para a infectologista Marisa Zenaide Ribeiro Gomes, do LaboratĂ³rio de Pesquisa em InfecĂ§Ă£o Hospitalar do Instituto Oswaldo Cruz (IOC/Fiocruz), o combate aos micro-organismos resistentes, dentro e fora do ambiente hospitalar, depende de um esforço conjunto das autoridades, dos profissionais de saĂºde e da populaĂ§Ă£o em geral. Confira abaixo a entrevista com a pesquisadora.
Gutemberg Brito

Em 2013, o LaboratĂ³rio de Pesquisa em InfecĂ§Ă£o Hospitalar do IOC identificou, pela primeira vez no Brasil, bactĂ©rias produtoras de NDM (New Delhi Metallobetalactamase), enzima que torna os micro-organismos resistentes a antibiĂ³ticos
Por que o problema das bactĂ©rias resistentes a antibiĂ³ticos se tornou tĂ£o grave?
Esta situaĂ§Ă£o vem se agravando por causa do uso abusivo de antibiĂ³ticos, o que ocorre por vĂ¡rios motivos. Mesmo na situaĂ§Ă£o de dĂºvida sobre a origem de uma infecĂ§Ă£o simples, como um resfriado, muitas vezes os antibiĂ³ticos acabam sendo recomendados. Nos hospitais, em funĂ§Ă£o das dificuldades para o diagnĂ³stico microbiolĂ³gico rĂ¡pido dos agentes causadores das infecções, se torna freqĂ¼ente a realizaĂ§Ă£o de tratamento antibiĂ³tico empĂrico, ou seja, sem a identificaĂ§Ă£o da bactĂ©ria que provoca a doença. Com o uso indiscriminado, as bactĂ©rias apresentam resistĂªncia e hĂ¡ necessidade de usar ainda mais antibiĂ³ticos nos tratamentos. O resultado Ă© que precisamos voltar a utilizar drogas que jĂ¡ tinham saĂdo do mercado.
Quais os riscos se nĂ£o houver avanços no combate Ă resistĂªncia a antibiĂ³ticos?
Nos Ăºltimos 20 anos, o desenvolvimento de novos antibiĂ³ticos nĂ£o acompanhou a rapidez com que os micro-organismos desenvolveram resistĂªncia. JĂ¡ existem bactĂ©rias contra as quais nĂ£o hĂ¡ recursos terapĂªuticos disponĂveis. Qualquer pessoa pode ser atendida na emergĂªncia de um grande hospital, adquirir uma infecĂ§Ă£o com micro-organismo resistente e ter dificuldade de se recuperar ou atĂ© morrer. As bactĂ©rias resistentes tambĂ©m nĂ£o estĂ£o restritas aos hospitais, podendo ser adquiridas no ambiente comunitĂ¡rio, ou seja, fora dos serviços de saĂºde. Se nĂ£o houver antibiĂ³ticos para tratar as infecções, estaremos ameaçando a medicina como um todo. Tratamentos mais complexos – como a terapia contra o cĂ¢ncer, o transplante de Ă³rgĂ£os e as cirurgias cardĂacas, para citar os tratamentos mais caros – correm o risco de ser comprometidos se nĂ£o for possĂvel tratar as infecções que podem ocorrer apĂ³s estes procedimentos.
Considerando que nĂ£o se pode deixar de usar antibiĂ³ticos, o que deve ser feito?
As medidas para minimizar o desenvolvimento de resistĂªncia antibiĂ³tica interessam a todas as especialidades mĂ©dicas e, portanto, todos que participam da assistĂªncia Ă saĂºde devem estar atentos e contribuir para as ações de prevenĂ§Ă£o e controle. Todo uso de antibiĂ³ticos nos hospitais deve ser notificado, no momento da prescriĂ§Ă£o, Ă s Comissões de Controle de InfecĂ§Ă£o Hospitalar (CCIHs). Assim, elas poderĂ£o adotar medidas para adequar o tratamento Ă s polĂticas de uso de antibiĂ³ticos recomendadas para suas unidades. As CCIHs devem desenvolver e atualizar sistematicamente rotinas de tratamento para as infecções mais frequentes e de maior risco nas diferentes Ă¡reas do hospital, considerando o perfil microbiolĂ³gico destas infecções e o histĂ³rico de consumo de antibiĂ³ticos.
Como as bactĂ©rias desenvolvem resistĂªncia aos medicamentos?
As bactĂ©rias sĂ£o organismos unicelulares, mas que tĂªm uma capacidade de organizaĂ§Ă£o e comunicaĂ§Ă£o muito grande. Tentando explicar de uma forma bem simplificada, quando uma delas adquire um gene de resistĂªncia a um determinado antibiĂ³tico, ela transmite essa caracterĂstica para as gerações seguintes e tambĂ©m para as ‘amigas e vizinhas’ – as bactĂ©rias prĂ³ximas, que podem ser atĂ© mesmo de outros gĂªneros e espĂ©cies. Portanto, as bactĂ©rias podem se tornar resistentes por uma mutaĂ§Ă£o genĂ©tica ou pela aquisiĂ§Ă£o de um gene de outro micro-organismo, pois sĂ£o capazes de transmitir estes mecanismos de defesa entre elas.
De que forma as bactĂ©rias resistentes sĂ£o transmitidas nos hospitais?
As bactĂ©rias tendem a ser mais resistentes dentro dos hospitais porque nestes locais hĂ¡ um uso maior de antibiĂ³ticos. A transmissĂ£o pode ocorrer de um paciente para outro, a partir de uma superfĂcie contaminada ou atĂ© mesmo entre partes diferentes do corpo da mesma pessoa. O importante Ă© que estes micro-organismos sĂ£o transmitidos sobretudo pelo contato, por isso higienizar as mĂ£os Ă© a principal medida de prevenĂ§Ă£o. Em infecções hospitalares, dizemos que as mĂ£os participam ativamente da transmissĂ£o dos micro-organismos, porque elas tocam o maior nĂºmero de superfĂcies e pacientes. No entanto, outros tipos de contato – como, por exemplo, o toque entre superfĂcies de equipamentos e pacientes – tambĂ©m podem ser responsĂ¡veis pela disseminaĂ§Ă£o das bactĂ©rias. DaĂ a importĂ¢ncia da higiene de superfĂcies clĂnicas e da desinfecĂ§Ă£o e esterilizaĂ§Ă£o de equipamentos mĂ©dico-hospitalares.
O que mais pode ser feito para prevenir a disseminaĂ§Ă£o das bactĂ©rias resistentes?
A higiene das mĂ£os Ă© uma medida que precisa ser adotada sistematicamente por profissionais de saĂºde, acompanhantes e visitantes sempre antes e apĂ³s o contato com pacientes e superfĂcies hospitalares. AlĂ©m disso, em casos especĂficos, Ă© recomendado uso de luvas, capotes e mĂ¡scaras, conforme a situaĂ§Ă£o de cada paciente. As informações sobre como prevenir infecções hospitalares devem ser conhecidas nĂ£o apenas pelo pessoal da Ă¡rea de saĂºde, mas tambĂ©m por recepcionistas, profissionais de limpeza, cozinheiros, enfim, todos que trabalham ou frequentam o hospital.
Como as pessoas podem contribuir neste processo?
A automedicaĂ§Ă£o Ă© uma questĂ£o crĂtica: Ă© preciso ir ao mĂ©dico para saber se realmente Ă© necessĂ¡rio tomar antibiĂ³ticos. Nas doenças provocadas por infecções virais, por exemplo, estes medicamentos nĂ£o tĂªm nenhuma efetividade. Quando hĂ¡ indicaĂ§Ă£o de usar antibiĂ³ticos, Ă© importante tomar os remĂ©dios na hora certa e fazer o tratamento durante todo o perĂodo recomendado, sem interrupĂ§Ă£o. AntibiĂ³ticos tambĂ©m nĂ£o devem ser jogados no lixo comum, para nĂ£o contaminar o meio ambiente. AlĂ©m de tudo isso, deve haver cuidados especiais quando as pessoas vĂ£o a um hospital. O ideal Ă© evitar o excesso de visitantes e acompanhantes e nĂ£o manter contato com outros pacientes. Em caso de dĂºvidas, os profissionais de saĂºde devem ser consultados.
MaĂra Menezes
15/05/2014
Autorizada a reproduĂ§Ă£o sem fins lucrativos desde que citada a fonte (ComunicaĂ§Ă£o / Instituto Oswaldo Cruz).
Especialista alertou que o uso indiscriminado de antibiĂ³ticos Ă© um dos problemas mais importantes a ser enfrentado
Este ano, o Dia de Combate Ă InfecĂ§Ă£o Hospitalar, celebrado em 15 de maio, foi precedido pela publicaĂ§Ă£o de um relatĂ³rio da OrganizaĂ§Ă£o Mundial da SaĂºde (OMS) que aponta que as bactĂ©rias resistentes a antibiĂ³ticos sĂ£o uma ameaça Ă saĂºde pĂºblica em todo o mundo. O documento mostrou que, em todas as regiões do planeta, jĂ¡ existem micro-organismos insensĂveis atĂ© mesmo Ă s drogas utilizadas como â€˜Ăºltimo recurso’. Segundo a OMS, sem medidas urgentes, hĂ¡ o risco de que doenças hoje consideradas menores voltem a ser fatais. Para a infectologista Marisa Zenaide Ribeiro Gomes, do LaboratĂ³rio de Pesquisa em InfecĂ§Ă£o Hospitalar do Instituto Oswaldo Cruz (IOC/Fiocruz), o combate aos micro-organismos resistentes, dentro e fora do ambiente hospitalar, depende de um esforço conjunto das autoridades, dos profissionais de saĂºde e da populaĂ§Ă£o em geral. Confira abaixo a entrevista com a pesquisadora.
 Gutemberg Brito
 
Em 2013, o LaboratĂ³rio de Pesquisa em InfecĂ§Ă£o Hospitalar do IOC identificou, pela primeira vez no Brasil, bactĂ©rias produtoras de NDM (New Delhi Metallobetalactamase), enzima que torna os micro-organismos resistentes a antibiĂ³ticos
Por que o problema das bactĂ©rias resistentes a antibiĂ³ticos se tornou tĂ£o grave?
Esta situaĂ§Ă£o vem se agravando por causa do uso abusivo de antibiĂ³ticos, o que ocorre por vĂ¡rios motivos. Mesmo na situaĂ§Ă£o de dĂºvida sobre a origem de uma infecĂ§Ă£o simples, como um resfriado, muitas vezes os antibiĂ³ticos acabam sendo recomendados. Nos hospitais, em funĂ§Ă£o das dificuldades para o diagnĂ³stico microbiolĂ³gico rĂ¡pido dos agentes causadores das infecções, se torna freqĂ¼ente a realizaĂ§Ă£o de tratamento antibiĂ³tico empĂrico, ou seja, sem a identificaĂ§Ă£o da bactĂ©ria que provoca a doença. Com o uso indiscriminado, as bactĂ©rias apresentam resistĂªncia e hĂ¡ necessidade de usar ainda mais antibiĂ³ticos nos tratamentos. O resultado Ă© que precisamos voltar a utilizar drogas que jĂ¡ tinham saĂdo do mercado.
Quais os riscos se nĂ£o houver avanços no combate Ă resistĂªncia a antibiĂ³ticos?
Nos Ăºltimos 20 anos, o desenvolvimento de novos antibiĂ³ticos nĂ£o acompanhou a rapidez com que os micro-organismos desenvolveram resistĂªncia. JĂ¡ existem bactĂ©rias contra as quais nĂ£o hĂ¡ recursos terapĂªuticos disponĂveis. Qualquer pessoa pode ser atendida na emergĂªncia de um grande hospital, adquirir uma infecĂ§Ă£o com micro-organismo resistente e ter dificuldade de se recuperar ou atĂ© morrer. As bactĂ©rias resistentes tambĂ©m nĂ£o estĂ£o restritas aos hospitais, podendo ser adquiridas no ambiente comunitĂ¡rio, ou seja, fora dos serviços de saĂºde. Se nĂ£o houver antibiĂ³ticos para tratar as infecções, estaremos ameaçando a medicina como um todo. Tratamentos mais complexos – como a terapia contra o cĂ¢ncer, o transplante de Ă³rgĂ£os e as cirurgias cardĂacas, para citar os tratamentos mais caros – correm o risco de ser comprometidos se nĂ£o for possĂvel tratar as infecções que podem ocorrer apĂ³s estes procedimentos.
Considerando que nĂ£o se pode deixar de usar antibiĂ³ticos, o que deve ser feito?
As medidas para minimizar o desenvolvimento de resistĂªncia antibiĂ³tica interessam a todas as especialidades mĂ©dicas e, portanto, todos que participam da assistĂªncia Ă saĂºde devem estar atentos e contribuir para as ações de prevenĂ§Ă£o e controle. Todo uso de antibiĂ³ticos nos hospitais deve ser notificado, no momento da prescriĂ§Ă£o, Ă s Comissões de Controle de InfecĂ§Ă£o Hospitalar (CCIHs). Assim, elas poderĂ£o adotar medidas para adequar o tratamento Ă s polĂticas de uso de antibiĂ³ticos recomendadas para suas unidades. As CCIHs devem desenvolver e atualizar sistematicamente rotinas de tratamento para as infecções mais frequentes e de maior risco nas diferentes Ă¡reas do hospital, considerando o perfil microbiolĂ³gico destas infecções e o histĂ³rico de consumo de antibiĂ³ticos.
Como as bactĂ©rias desenvolvem resistĂªncia aos medicamentos?
As bactĂ©rias sĂ£o organismos unicelulares, mas que tĂªm uma capacidade de organizaĂ§Ă£o e comunicaĂ§Ă£o muito grande. Tentando explicar de uma forma bem simplificada, quando uma delas adquire um gene de resistĂªncia a um determinado antibiĂ³tico, ela transmite essa caracterĂstica para as gerações seguintes e tambĂ©m para as ‘amigas e vizinhas’ – as bactĂ©rias prĂ³ximas, que podem ser atĂ© mesmo de outros gĂªneros e espĂ©cies. Portanto, as bactĂ©rias podem se tornar resistentes por uma mutaĂ§Ă£o genĂ©tica ou pela aquisiĂ§Ă£o de um gene de outro micro-organismo, pois sĂ£o capazes de transmitir estes mecanismos de defesa entre elas.
De que forma as bactĂ©rias resistentes sĂ£o transmitidas nos hospitais?
As bactĂ©rias tendem a ser mais resistentes dentro dos hospitais porque nestes locais hĂ¡ um uso maior de antibiĂ³ticos. A transmissĂ£o pode ocorrer de um paciente para outro, a partir de uma superfĂcie contaminada ou atĂ© mesmo entre partes diferentes do corpo da mesma pessoa. O importante Ă© que estes micro-organismos sĂ£o transmitidos sobretudo pelo contato, por isso higienizar as mĂ£os Ă© a principal medida de prevenĂ§Ă£o. Em infecções hospitalares, dizemos que as mĂ£os participam ativamente da transmissĂ£o dos micro-organismos, porque elas tocam o maior nĂºmero de superfĂcies e pacientes. No entanto, outros tipos de contato – como, por exemplo, o toque entre superfĂcies de equipamentos e pacientes – tambĂ©m podem ser responsĂ¡veis pela disseminaĂ§Ă£o das bactĂ©rias. DaĂ a importĂ¢ncia da higiene de superfĂcies clĂnicas e da desinfecĂ§Ă£o e esterilizaĂ§Ă£o de equipamentos mĂ©dico-hospitalares.
O que mais pode ser feito para prevenir a disseminaĂ§Ă£o das bactĂ©rias resistentes?
A higiene das mĂ£os Ă© uma medida que precisa ser adotada sistematicamente por profissionais de saĂºde, acompanhantes e visitantes sempre antes e apĂ³s o contato com pacientes e superfĂcies hospitalares. AlĂ©m disso, em casos especĂficos, Ă© recomendado uso de luvas, capotes e mĂ¡scaras, conforme a situaĂ§Ă£o de cada paciente. As informações sobre como prevenir infecções hospitalares devem ser conhecidas nĂ£o apenas pelo pessoal da Ă¡rea de saĂºde, mas tambĂ©m por recepcionistas, profissionais de limpeza, cozinheiros, enfim, todos que trabalham ou frequentam o hospital.
Como as pessoas podem contribuir neste processo?
A automedicaĂ§Ă£o Ă© uma questĂ£o crĂtica: Ă© preciso ir ao mĂ©dico para saber se realmente Ă© necessĂ¡rio tomar antibiĂ³ticos. Nas doenças provocadas por infecções virais, por exemplo, estes medicamentos nĂ£o tĂªm nenhuma efetividade. Quando hĂ¡ indicaĂ§Ă£o de usar antibiĂ³ticos, Ă© importante tomar os remĂ©dios na hora certa e fazer o tratamento durante todo o perĂodo recomendado, sem interrupĂ§Ă£o. AntibiĂ³ticos tambĂ©m nĂ£o devem ser jogados no lixo comum, para nĂ£o contaminar o meio ambiente. AlĂ©m de tudo isso, deve haver cuidados especiais quando as pessoas vĂ£o a um hospital. O ideal Ă© evitar o excesso de visitantes e acompanhantes e nĂ£o manter contato com outros pacientes. Em caso de dĂºvidas, os profissionais de saĂºde devem ser consultados.
MaĂra Menezes
15/05/2014
Autorizada a reproduĂ§Ă£o sem fins lucrativos desde que citada a fonte (ComunicaĂ§Ă£o / Instituto Oswaldo Cruz).
Permitida a reproduĂ§Ă£o sem fins lucrativos do texto desde que citada a fonte (ComunicaĂ§Ă£o / Instituto Oswaldo Cruz)